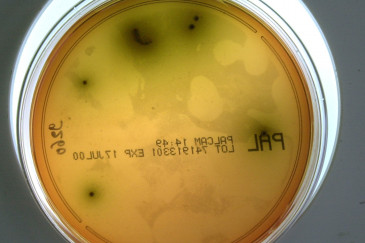

Carrefour : rappel massif de plats préparés et de snacks, ils pourraient être contaminés à la listeria
Vendredi 3 avril 2026, Rappel Conso s'est fait l'écho d'un rappel de produits concernant l'enseigne Carrefour. Sept plats préparés, en vente du 30 mars au 3 avril, seraient contaminés à la listeria.